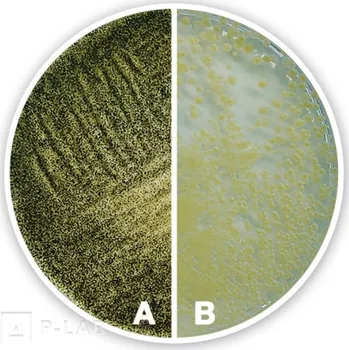
Hnojivo Agar Sabouraud 4% glukózový (Popis: acc. to Ph. Eur./USP, pro mikrobiologii, Balení: 500 g, Obal: plast)

Hnojiva
Vybírejte z hnojiv na rajčata, okurky, trávník či orchideje. Pomůžeme vám vybrat správné hnojivo, jeho formu a poradíme jak ho správně aplikovat.
Určení hnojiva
Univerzální hnojivo můžete použít na jedlé i nejedlé rostliny. Je ale lepší používat ho jen když není nic jiného po ruce nebo na prohnojení celého záhonu, třeba před sázením či setím. Pokud už vám v záhonu něco roste, vždy je lepší použít specializované hnojivo na daný druh rostliny.
Okrasné rostliny a trávník
Ovoce, zelenina a bylinky
- Ovoce a zelenina
- Ovocné stromy
- Borůvky a brusinky
- Citrusy
- Jahody
- Vinná réva
- Brambory
- Cibule a česnek
- Rajčata a papriky
- Okurky
- Bylinky
Největší rozdíl mezi hnojivy na ovoce a zeleninu, tedy pro jedlé rostliny a pro ty okrasné je v tom, že plody budete konzumovat, tudíž nesmí být hnojivo pro člověka jedovaté, nebo je třeba alespoň dodržet délku lhůty od posledního hnojení, kdy nesmíte plody z rostlin konzumovat. Vybírejte proto na užitkovou zahradu i na tu okrasnou, právě na ně určená hnojiva.
Typ hnojiva
- Organická hnojiva – Jsou rostlinného nebo živočišného původu (např. kompost, hnůj, rostlinné výluhy, zelené hnojení a další). Podporují tvorbu humusu v půdě a zvyšují její úrodnost.
- Minerální hnojiva – Tzv. anorganická hnojiva se skládají ze solí (draslík, vápník, fosfát, sulfát, chlorid). Toto hnojivo může být uměle vytvořené nebo přírodního původu (dolomitský vápenec). Minerální hnojiva mají rychlý účinek, ale nezvyšují dlouhodobou úrodnost půdy, a mohou i bránit v práci užitečným mikroorganismům.
- Organicko-minerální hnojiva – Kombinují v sobě dva výše zmíněné druhy tak, aby se potlačily negativní vlastnosti a maximálně využili ty pozitivní.
- Stimulátory – Používají se pro rychlejší zakořenění při řízkování. Spodek rostliny se namáčí do stimulátoru a poté zasadí do hlíny. Vhodné jsou pro bylinné i dřevnaté řízky.
Forma hnojiva
Většina hnojiv se aplikují zapracováním do zeminy, jsou ale i tzv. hnojiva na list, které se nepřidávají do hlíny ale pomocí rozprašovačem přímo na list. Tato hnojiva jsou většinou doplňková.
- Tekutá hnojiva – Mají pestřejší složení a jsou jednoduchá na aplikaci. Jsou vhodná pro zálivku i postřik na list a lze je použít kdykoliv během vegetačního období. Nabízejí specializované složení pro různé druhy rostlin a jsou účinná při řešení specifických problémů, jako je nedostatek určitých živin. Jejich velkou výhodou je rychlé vstřebávání rostlinami.
- Krystalická hnojiva – Rozpouštějí se ve vodě, kterou následně zalejete půdu. Jsou vhodná pro všechny druhy rostlin a poskytují komplexní výživu včetně mikroprvků ve formě, která je rostlinám snadno dostupná. Jejich použití je jednoduché a efektivní.
- Prášková hnojiva – Například Ledek amonný 27% N, se aplikuje především na půdu. Vzhledem k obsahu malých částic může ulpívat na listech, proto je třeba dbát na správnou aplikaci, aby nedošlo k poškození rostlin. Tato hnojiva jsou vhodná pro širokou škálu plodin a mohou být aplikována v různých fázích růstu rostlin.
- Pevná hnojiva – Účinkují dlouhodobě a zásobují rostliny živinami postupně. Pro jejich uvolňování do půdy musí být teplota vyšší než 16 °C. Neméně důležité je pravidelné zalévání. Pevná hnojiva mají více forem např. tyčinky, tablety či granule.
V případě sypkých hnojiv lze použít tzv. rozmetadlo, které vám hnojení velmi usnadní, hlavně pokud máte větší zahradu.
Složení hnojiva
Hnojiva lze v základu rozdělit na jednosložková a vícesložková. Využívají se podle potřeby na konkrétní typ problému.
Jednosložková hnojiva
Nazývají se také jednoduchá nebo jednokomponentní, obsahují pouze jednu hlavní živinu. Používají se jako základní hnojiva nebo když není k dispozici vhodné vícesložkové hnojivo. Jsou vhodná pro cílenou aplikaci při nedostatku konkrétní živiny v půdě.
Vícesložková hnojiva
Vícesložková hnojiva obsahují více hlavních živin (makroprvků) a často i doplňkové živiny (mikroprvky). Jejich použití zjednodušuje a zefektivňuje proces hnojení. Dodávají se většinou v granulované podobě s rovnoměrným zastoupením živin. Příkladem je NPK (dusík, fosfor a draslík), které je určeno k základnímu hnojení ovoce a zeleniny před výsadbou a k přihnojování během vegetace.
Tipy ke hnojení
- Velmi důležité je dodržovat návod k použití, tedy jaké množství hnojiva použít na jedno hnojení. Rozhodně neplatí, že čím více pohnojíte tím lepší bude úroda. Příliš hnojiva může rostlinu tzv. spálit a to třeba i v případě hnojením vlastním kompostem ze zahrádky.
- Velmi důležitá je doba, kdy budete hnojit. Rostliny potřebují jiné látky v zimě, když odpočívají, na jaře, když se probouzejí, v době plození či kvetení, nebo po odkvětu.